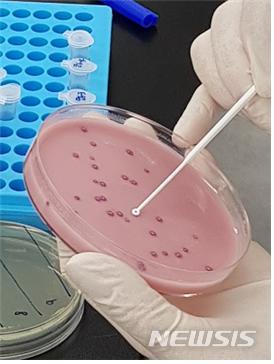
【대구=뉴시스】정창오 기자 = 자료사진. 대구시 보건환경연구원의 식중독 원인균 보균검사 모습이다. 2018.02.24.(사진=대구시 보건환경연구원 제공)&nbsp; photo@newsis.com

【대구=뉴시스】정창오 기자 = 자료사진. 대구시 보건환경연구원의 식중독 원인균 보균검사 모습이다. 2018.02.24.(사진=대구시 보건환경연구원 제공) [email protected]
【대구=뉴시스】정창오 기자 = 대구시 보건환경연구원은 신학기 개학을 맞아 학교 집단식중독 발생을 사전에 예방하기 위해 오는 26일부터 3월 16일까지 급식 조리종사자들을 대상으로 2018년도 보균 실태조사를 실시한다.
이번 보균조사는 2015년부터 2017년까지 최근 3년간 집단 식중독 발생이 있었던 학교의 급식 조리종사자 전원을 대상으로 실시하며 장출혈성대장균, 세균성이질, 노로바이러스 등을 포함한 식중독 원인균 15종의 보균 여부를 집중 조사하게 된다.
2017년도 보균 실태조사(식중독 발생기간: 2014년~ 2016년)에서는 병원성대장균 등 9명이 양성으로 나와 보균자를 완전히 치료해 병원체 미 보유 확인 후 업무에 복귀시킨 바 있다.
이번 보균 실태조사도 검사결과에 따라서 보균자에 대한 적극적인 치료를 권고해 병원체 미 보유 확인 후 업무에 복귀시켜 학교급식 조리종사자들에 의한 집단식중독 발생을 사전에 차단할 계획이다.
김경태 대구보건환경연구원 보건연구부장은 “이번 조리종사자 보균 실태조사를 통해 학교급식으로 인한 집단 식중독 발생이 더 이상 일어나지 않기를 기대하며 아울러 식중독 예방을 위해 개인 손씻기 생활화를 실천해 줄 것”을 당부했다.
[email protected]
이번 보균조사는 2015년부터 2017년까지 최근 3년간 집단 식중독 발생이 있었던 학교의 급식 조리종사자 전원을 대상으로 실시하며 장출혈성대장균, 세균성이질, 노로바이러스 등을 포함한 식중독 원인균 15종의 보균 여부를 집중 조사하게 된다.
2017년도 보균 실태조사(식중독 발생기간: 2014년~ 2016년)에서는 병원성대장균 등 9명이 양성으로 나와 보균자를 완전히 치료해 병원체 미 보유 확인 후 업무에 복귀시킨 바 있다.
이번 보균 실태조사도 검사결과에 따라서 보균자에 대한 적극적인 치료를 권고해 병원체 미 보유 확인 후 업무에 복귀시켜 학교급식 조리종사자들에 의한 집단식중독 발생을 사전에 차단할 계획이다.
김경태 대구보건환경연구원 보건연구부장은 “이번 조리종사자 보균 실태조사를 통해 학교급식으로 인한 집단 식중독 발생이 더 이상 일어나지 않기를 기대하며 아울러 식중독 예방을 위해 개인 손씻기 생활화를 실천해 줄 것”을 당부했다.
[email protected]
